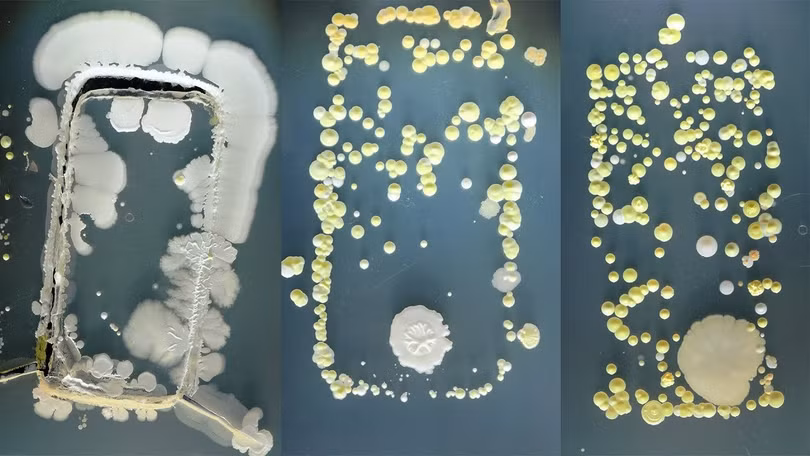
Vi khuẩn tìm thấy trên ốp lưng điện thoại.

Theo một nghiên cứu của Đại học Arizona, Hoa Kỳ vào năm 2022, một chiếc điện thoại di động có thể chứa tới hơn 17.000 loại vi khuẩn. Ở mức độ này, nó bẩn hơn gấp 10 lần so với hầu hết các bồn cầu trong nhà vệ sinh.
Con số 10 cũng được chỉ ra trong một nghiên cứu của Đại học Surrey, Anh Quốc vào năm 2014. Theo đó, một số sinh viên theo học chuyên ngành vi sinh tại đây đã làm một thí nghiệm nhỏ. Họ thu thập các mẫu ốp điện thoại của sinh viên khác trong trường rồi nhúng chúng vào môi trường thạch tăng trưởng.
Thạch sẽ cung cấp cho vi khuẩn trên ốp điện thoại môi trường để phát triển thành khuẩn lạc. Chỉ 3 ngày sau, những chủng vi khuẩn tồn tại trên ốp điện thoại đã lộ diện và có thể nhìn thấy được bằng mắt thường. Số lượng của chúng gấp 10 lần so với thí nghiệm tương tự với nắp bồn cầu.
Vi khuẩn tìm thấy trên ốp lưng điện thoại.
Năm 2018, một nghiên cứu tương tự được thực hiện bởi công ty bảo hiểm Insurance2go, Anh Quốc cũng khẳng định điện thoại di động bẩn gấp 10 lần bồn cầu. Họ đã so sánh số lượng vi khuẩn trên màn hình điện thoại iPhone, Samsung Galaxy và Google Pixel để kiểm tra xem mẫu điện thoại nào dễ bám bẩn nhất.
Kết quả cho thấy điện thoại Samsung chứa tới 100 CFU (đơn vị hình thành khuẩn lạc – dùng để đánh giá số lượng tế bào vi khuẩn hoặc nấm) trên mỗi cm 2 màn hình. Theo sau đó là iPhone, 40 CFU/cm 2 và màn hình Google Pixel sạch nhất cũng chứa 12 CFU/cm 2 vi khuẩn và nấm.
Các khu vực khác của điện thoại cũng bẩn không kém, bao gồm mặt sau, phím khóa màn hình và nút home. Trong so sánh, bàn phím và chuột ở văn phòng có khoảng 5 CFU/cm 2 nấm và vi khuẩn. Con số ở bệ ngồi bồn cầu 10 CFU/cm 2 :
Tại sao điện thoại lại bẩn đến vậy?
Một cuộc khảo sát năm 2019 cho thấy cứ 3 người thì có 2 người thừa nhận họ có thói quen sử dụng điện thoại trong nhà vệ sinh. Vì vậy, không có gì ngạc nhiên khi các nghiên cứu phát hiện ra rằng điện thoại di động của chúng ta còn bẩn hơn cả bồn cầu.
"Ít ra thì bồn cầu còn được cọ rửa thường xuyên trong khi điện thoại và nhiều vật dụng cầm tay khác như máy nghe nhạc, điều khiển từ xa lại không thường xuyên được lau chùi bởi chúng là những thiết bị điện tử", Charles Gerba, một nhà vi sinh vật học tại Đại học Arizona cho biết.
Và không chỉ mang vào nhà vệ sinh, chúng ta còn thường đặt điện thoại lên mọi bề mặt xung quanh mình, từ bàn bếp để mở Youtube khi nấu nướng, nơi trước đó từng có đồ ăn sống, cho đến mặt bàn làm việc ở công ty, nơi chỉ được bạn thực sự lau chùi và dọn dẹp một năm một lần.
Chúng ta cũng vừa ăn vừa sử dụng điện thoại, vừa cầm gà rán đầy mỡ đã vuốt lên màn hình điện thoại, vừa bóc tôm xong đã nhắn tin với bạn bè… Ước tính mỗi ngày bạn đều chạm vào điện thoại của mình từ hàng trăm nếu không muốn nói là hàng nghìn lần. Và trong khi chúng ta đều rửa tay với xà phòng sau khi chạm vào bồn cầu trong nhà vệ sinh, chẳng mấy ai để ý đến việc phải rửa tay sau khi dùng điện thoại.
Đó chính là một lỗ hổng trong quy trình dịch tễ của thế kỷ 21, cho phép các mầm bệnh lẻn qua để xâm nhập và gây bệnh cho bạn.
Cách để khử khuẩn điện thoại an toàn
Người dùng có thể lấy một chiếc khăn vải hoặc khăn giấy, thấm cồn 70 độ và lau một lượt trên màn hình cảm ứng, vỏ và cả ốp điện thoại.

Lưu ý, không xịt cồn trực tiếp vào điện thoại và giữ chất lỏng cách xa các điểm kết nối hoặc các lỗ hở khác của điện thoại. Tuyệt đối tránh sử dụng thuốc tẩy hoặc chất tẩy rửa có tình mài mòn vì chúng có thể làm hỏng màn hình cảm ứng của bạn.
Trong khi một số loại điện thoại có tính năng chống nước có thể được rửa xà phòng như cách bạn rửa tay, điều này không được các chuyên gia khuyến cáo. Nếu bạn thực sự muốn tiêu diệt vi khuẩn trên điện thoại của mình một cách triệt để hơn, bạn có thể lau cồn nhiều lần trong ngày hoặc sử dụng thiết bị khử trùng điện thoại chuyên dụng.
Các thiết bị này phát ra tia UVC, một loại bức xạ cũng thường được sử dụng để khử khuẩn ở bệnh viện vào ban đêm, có tác dụng diệt khuẩn mạnh. Tuy nhiên, hãy cẩn thận với loại bức xạ này, đừng để chúng tiếp xúc với mắt và da, vì UVC có năng lượng cao cũng có thể gây hại cho bạn.







































